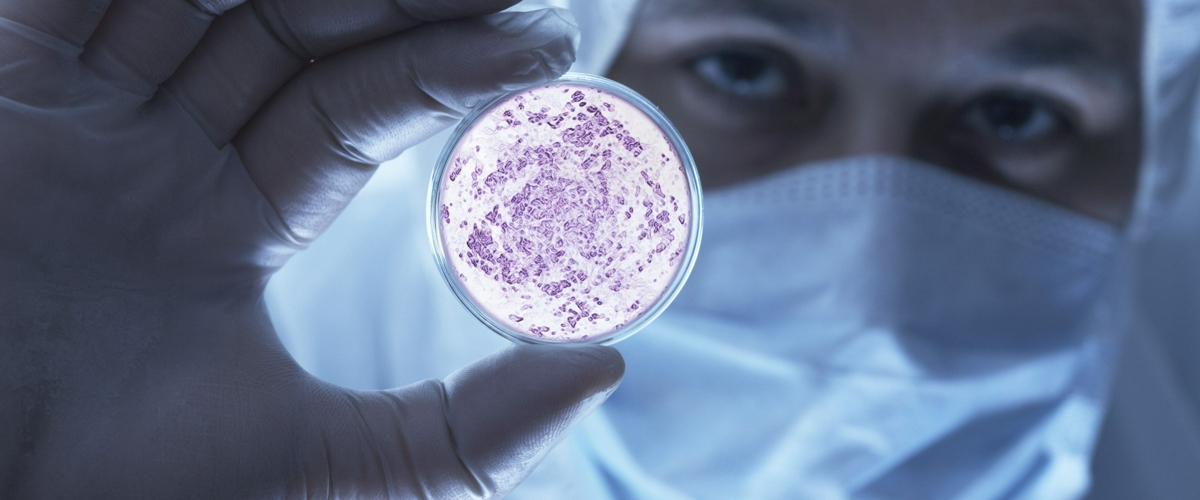
TODO:

Микробиота кишечника, которая содержит триллионы микроорганизмов, отличается у здоровых людей и пациентов на фоне развития того или иного заболевания. Команда ученых из Левенского католического университета (Бельгия) сконцентрировалась на заболеваниях кишечника и печени и определила измененную конфигурацию микробиоты у этих групп пациентов — энтеротип В2.
Исследования показали, что у людей с энтеротипом В2 микробиота кишечника характеризуется низким содержанием бактерий и биоразнообразием. Например, у них наблюдается дефицит некоторых противовоспалительных бактерий, включая Faecalibacterium.
Энтеротип В2 обнаруживается у 38-78% пациентов с воспалительными заболеваниями кишечника и первичным склерозирующим холангитом — хронической патологией печени, выяснили авторы.
Этот энтеротип наблюдался и у 13% здоровых людей, но даже у них был зафиксирован более высокий уровень общего воспаления, подчеркнули исследователи.
Ранее команда обнаружила, что подобное состояние микробиоты связано с более низким качеством жизни людей и даже риском депрессии. Энтеротип В2 был обнаружен примерно у 26% людей с депрессией.
«Вероятно, существует значительное совпадение в изменениях микробиоты в этих группах пациентов», — предположил ученый Йерун Раес. Взаимосвязь энтеротипа В2 с природой депрессии ученые планируют изучать в будущих исследованиях. Пока нельзя однозначно утверждать, что восприимчивость человека к заболеванию определяется на основе его энтеротипа.
Недавно в США представили результаты метаанализа десятка научных исследований, которые объясняют взаимосвязь тяжелых болезней и микробиоты кишечника. Другая работа доказывает, что микрофлора кишечника с детства определяет риск рака.